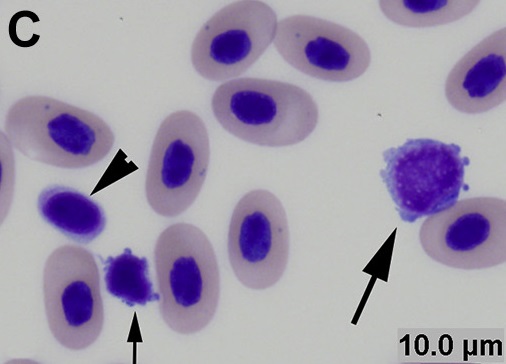
\ Hematologi Ikan bagian 1

Limfosit adalah leukosit yang berfungsi untuk.
Jika kamu sedang mencari artikel limfosit adalah leukosit yang berfungsi untuk terbaru, berarti kamu telah berada di blog yang tepat. Yuk langsung saja kita simak ulasan limfosit adalah leukosit yang berfungsi untuk berikut ini.
 Jala Hoaks Jakarta From jalahoaks.jakarta.go.id
Jala Hoaks Jakarta From jalahoaks.jakarta.go.id
Intepretasi nilai leukosit dan limfosit pada hasil pemeriksaan laboratorium.
Sel t dan sel b. Limfosit terbentuk di dalam sumsum tulang. Limfosit adalah salah satu jenis sel darah putih yang ada dalam peredaran darah kita. Eusinofil berfungsi sebagai fagosit lemah dan berperan dalam pembuangan racun penyebab radang pada jaringan yang cedera. 1, 2, dan 3 b.
 Source: hisham.id
Source: hisham.id
Sel darah putih ini berfungsi untuk membantu tubuh melawan berbagai penyakit infeksi sebagai bagian dari sistem kekebalan tubuh. Selain sel darah merah, tubuh manusia juga memiliki sel darah putih alias leukosit yang beragam jenis. Sementara itu, limfosit t bertanggung jawab untuk menghancurkan sel tubuh sendiri yang telah diserang virus atau menjadi kanker. Apakah leukosit tinggi selalu identik dengan infeksi bakteri dan limfosit infeksi virus? Sel t dan sel b.
Apakah leukosit tinggi selalu identik dengan infeksi bakteri dan limfosit infeksi virus?
Leukosit adalah sel lain yang terdapat di dalam darah. Limfosit terbentuk di dalam sumsum tulang. Sel t dan sel b. Kita ketahui bahwa sel darah putih berfungsi membantu melindungi tubuh terhadap penyakit dan melawan infeksi.
 Source: brainly.co.id
Source: brainly.co.id
Sementara itu, limfosit t bertanggung jawab untuk menghancurkan sel tubuh sendiri yang telah diserang virus atau menjadi kanker. Limfosit merupakan sel darah putih terbanyak kedua sesudah neutrofil. Limfosit adalah sel darah putih yang penting untuk menjaga sistem kekebalan tubuh. Limfosit adalah salah satu jenis sel darah putih yang ada dalam peredaran darah kita.
 Source: slideshare.net
Source: slideshare.net
Sementara sel t bekerja dengan menyerang sel tubuh yang sudah terpapar virus atau sel kanker. Dengan demikian, pilihan jawaban yang tepat adalah d. Sedangkan basofl berfungsi untuk menghasilkan histamin dan heparin. Limfosit juga dibagi menjadi dua macam yakni limfosit kecil dan limfosit besar.
 Source: jalahoaks.jakarta.go.id
Source: jalahoaks.jakarta.go.id
Leukosit adalah sel lain yang terdapat di dalam darah. Fungsi umum leukosit sangat berbeda dengan eritrosit. Limfosit juga dibagi menjadi dua macam yakni limfosit kecil dan limfosit besar. Yang merupakan fungsi dari sistem pertahanan tubuh adalah.
Monosit merupakan kelompok leukosit yang menjadi bagian dari sistem kekebalan tubuh.
Leukosit agranulosit juga dibagi menjadi 2 jenis yaitu limfosit dan monosit. Limfosit merupakan sel darah putih terbanyak kedua sesudah neutrofil. Sedangkan basofl berfungsi untuk menghasilkan histamin dan heparin. Intepretasi nilai leukosit dan limfosit pada hasil pemeriksaan laboratorium. Leukosit merupakan sel darah putih yang diproduksi oleh jaringan hemopoetik untuk jenis bergranula (polimorfonuklear) dan jaringan limpatik untuk jenis tak bergranula (mononuklear), berfungsi dalam sistem pertahanan tubuh terhadap infeksi (sutedjo, 2006).
 Source: slideshare.net
Source: slideshare.net
Leukosit adalah sel lain yang terdapat di dalam darah. Limfosit juga dibagi menjadi dua macam yakni limfosit kecil dan limfosit besar. Intepretasi nilai leukosit dan limfosit pada hasil pemeriksaan laboratorium. Limfosit adalah sel darah putih yang penting untuk menjaga sistem kekebalan tubuh. Kita ketahui bahwa sel darah putih berfungsi membantu melindungi tubuh terhadap penyakit dan melawan infeksi.
Limfosit juga dibagi menjadi dua macam yakni limfosit kecil dan limfosit besar.
Leukosit agranulosit juga dibagi menjadi 2 jenis yaitu limfosit dan monosit. Eusinofil berfungsi sebagai fagosit lemah dan berperan dalam pembuangan racun penyebab radang pada jaringan yang cedera. Sedangkan basofl berfungsi untuk menghasilkan histamin dan heparin. Fungsi umum leukosit sangat berbeda dengan eritrosit.
 Source: brainly.co.id
Source: brainly.co.id
Selain sel darah merah, tubuh manusia juga memiliki sel darah putih alias leukosit yang beragam jenis. Limfosit adalah sel darah putih yang penting untuk menjaga sistem kekebalan tubuh. Dengan demikian, pilihan jawaban yang tepat adalah d. Sel darah putih tidak berwarna, memiliki inti, dapat bergerak secara amoeboid, dan dapat menembus dinding kapiler atau diapedesis.
 Source: slideshare.net
Source: slideshare.net
2.1.2 regulasi limfosit fungsi utama limfosit adalah untuk meregulasi sistem imun. Limfosit adalah sejenis sel darah putih (wbc). T reg mengekspresikan cd4+ dan cd25+ yang berfungsi untuk mengontrol Limfosit b berfungsi membuat antibodi untuk melawan bakteri, virus, dan racun yang menyerang tubuh anda.
 Source: hisham.id
Source: hisham.id
Leukosit merupakan sel darah putih yang diproduksi oleh jaringan hemopoetik untuk jenis bergranula (polimorfonuklear) dan jaringan limpatik untuk jenis tak bergranula (mononuklear), berfungsi dalam sistem pertahanan tubuh terhadap infeksi (sutedjo, 2006). Leukosit agranulosit juga dibagi menjadi 2 jenis yaitu limfosit dan monosit. Sementara itu, limfosit t bertanggung jawab untuk menghancurkan sel tubuh sendiri yang telah diserang virus atau menjadi kanker. Sedangkan basofl berfungsi untuk menghasilkan histamin dan heparin.
T reg mengekspresikan cd4+ dan cd25+ yang berfungsi untuk mengontrol
Ada dua jenis utama limfosit, yaitu limfosit sel b dan sel t. 1, 2, dan 3 b. Ada dua jenis utama limfosit, yaitu limfosit sel b dan sel t. Limfosit terbagi menjadi 2 jenis, yaitu limfosit b dan limfosit t. Sementara sel t bekerja dengan menyerang sel tubuh yang sudah terpapar virus atau sel kanker.
 Source: hisham.id
Source: hisham.id
Sel darah putih (leukosit) adalah sel darah yang bertanggung jawab untuk pertahanan terhadap infeksi, baik sebagai produsen antibodi (limfosit), atau berpartisipasi dalam penghancuran mikroorganisme (neutrofil, eosinofil, basofil dan monosit). Limfosit adalah salah satu dari beberapa jenis sel pertahanan dalam tubuh dan termasuk dalam kelompok sel yang disebut leukosit atau sel darah putih. Sementara sel t bekerja dengan menyerang sel tubuh yang sudah terpapar virus atau sel kanker. Monosit merupakan kelompok leukosit yang menjadi bagian dari sistem kekebalan tubuh. Limfosit juga dibagi menjadi dua macam yakni limfosit kecil dan limfosit besar.
Dua puluh persen dari total jumlah leukosit manusia merupakan limfosit.
Kita ketahui bahwa sel darah putih berfungsi membantu melindungi tubuh terhadap penyakit dan melawan infeksi. Sementara itu, limfosit t bertanggung jawab untuk menghancurkan sel tubuh sendiri yang telah diserang virus atau menjadi kanker. 2.1.2 regulasi limfosit fungsi utama limfosit adalah untuk meregulasi sistem imun. Limfosit adalah sel darah putih yang penting untuk menjaga sistem kekebalan tubuh.
 Source: jalahoaks.jakarta.go.id
Source: jalahoaks.jakarta.go.id
Kita ketahui bahwa sel darah putih berfungsi membantu melindungi tubuh terhadap penyakit dan melawan infeksi. Sel darah putih tidak berwarna, memiliki inti, dapat bergerak secara amoeboid, dan dapat menembus dinding kapiler atau diapedesis. 1, 2, dan 3 b. Sementara sel t bekerja dengan menyerang sel tubuh yang sudah terpapar virus atau sel kanker.
 Source: catatandokterikan.com
Source: catatandokterikan.com
Eusinofil berfungsi sebagai fagosit lemah dan berperan dalam pembuangan racun penyebab radang pada jaringan yang cedera. Begitu juga dengan fungsi limfosit ini. Limfosit b berfungsi untuk memproduksi antibodi guna menyerang bakteri, virus, dan racun. Leukosit merupakan sel darah putih yang diproduksi oleh jaringan hemopoetik untuk jenis bergranula (polimorfonuklear) dan jaringan limpatik untuk jenis tak bergranula (mononuklear), berfungsi dalam sistem pertahanan tubuh terhadap infeksi (sutedjo, 2006).
 Source: brainly.co.id
Source: brainly.co.id
Sementara sel t bekerja dengan menyerang sel tubuh yang sudah terpapar virus atau sel kanker. Sedangkan basofl berfungsi untuk menghasilkan histamin dan heparin. Apa itu limfosit dan fungsinya. Sementara sel t bekerja dengan menyerang sel tubuh yang sudah terpapar virus atau sel kanker.
Dengan demikian, pilihan jawaban yang tepat adalah d.
Kita ketahui bahwa sel darah putih berfungsi membantu melindungi tubuh terhadap penyakit dan melawan infeksi. Kita ketahui bahwa sel darah putih berfungsi membantu melindungi tubuh terhadap penyakit dan melawan infeksi. Leukosit agranulosit juga dibagi menjadi 2 jenis yaitu limfosit dan monosit. Apa itu limfosit dan fungsinya. Sel darah putih tidak berwarna, memiliki inti, dapat bergerak secara amoeboid, dan dapat menembus dinding kapiler atau diapedesis.
 Source: slideshare.net
Source: slideshare.net
Limfosit adalah salah satu dari beberapa jenis sel pertahanan dalam tubuh dan termasuk dalam kelompok sel yang disebut leukosit atau sel darah putih. Sel t dan sel b. Intepretasi nilai leukosit dan limfosit pada hasil pemeriksaan laboratorium. Ujung bervariasi dari bentuk bulat atau oval ke bentuk berlekuk atau tapal kuda. Limfosit adalah sel darah putih yang penting untuk menjaga sistem kekebalan tubuh.
Eusinofil berfungsi sebagai fagosit lemah dan berperan dalam pembuangan racun penyebab radang pada jaringan yang cedera.
Limfosit adalah sejenis sel darah putih (wbc). Apa itu limfosit dan fungsinya. Ada dua jenis utama limfosit, yaitu limfosit sel b dan sel t. Namun, tidak semua infeksi bakteri ataupun virus menunjukkan gambaran patologik yang demikian.
Source: catatandokterikan.com
Source: catatandokterikan.com
Sementara sel t bekerja dengan menyerang sel tubuh yang sudah terpapar virus atau sel kanker. Dua puluh persen dari total jumlah leukosit manusia merupakan limfosit. Apa itu limfosit dan fungsinya. Monosit adalah leukosit agranular terbesar. Limfosit terbentuk di dalam sumsum tulang.
 Source: blogs.insanmedika.co.id
Source: blogs.insanmedika.co.id
Fungsi limfosit mendata jenis kuman yang dibunuh oleh monosit yaitu untuk membentuk sistem pertahanan (antibody) terhadap zat itu, sehingga ketika zat itu masuk kembali ke dalam tubuh di masa yang akan datang, akan mudah untuk dilawan. Warna monosit lebih muda dari inti limfosit. 2.1.2 regulasi limfosit fungsi utama limfosit adalah untuk meregulasi sistem imun. Leukosit adalah sel yang membentuk komponen darah. Ada dua jenis utama limfosit, yaitu limfosit sel b dan sel t.
 Source: brainly.co.id
Source: brainly.co.id
Monosit merupakan kelompok leukosit yang menjadi bagian dari sistem kekebalan tubuh. Sedangkan basofl berfungsi untuk menghasilkan histamin dan heparin. Fungsi limfosit mendata jenis kuman yang dibunuh oleh monosit yaitu untuk membentuk sistem pertahanan (antibody) terhadap zat itu, sehingga ketika zat itu masuk kembali ke dalam tubuh di masa yang akan datang, akan mudah untuk dilawan. Limfosit dibentuk di dalam sumsum tulang dan di limfa. Eusinofil berfungsi sebagai fagosit lemah dan berperan dalam pembuangan racun penyebab radang pada jaringan yang cedera.
Situs ini adalah komunitas terbuka bagi pengguna untuk membagikan apa yang mereka cari di internet, semua konten atau gambar di situs web ini hanya untuk penggunaan pribadi, sangat dilarang untuk menggunakan artikel ini untuk tujuan komersial, jika Anda adalah penulisnya dan menemukan gambar ini dibagikan tanpa izin Anda, silakan ajukan laporan DMCA kepada Kami.
Jika Anda menemukan situs ini lengkap, tolong dukung kami dengan membagikan postingan ini ke akun media sosial seperti Facebook, Instagram dan sebagainya atau bisa juga simpan halaman blog ini dengan judul limfosit adalah leukosit yang berfungsi untuk dengan menggunakan Ctrl + D untuk perangkat laptop dengan sistem operasi Windows atau Command + D untuk laptop dengan sistem operasi Apple. Jika Anda menggunakan smartphone, Anda juga dapat menggunakan menu laci dari browser yang Anda gunakan. Baik itu sistem operasi Windows, Mac, iOS, atau Android, Anda tetap dapat menandai situs web ini.





